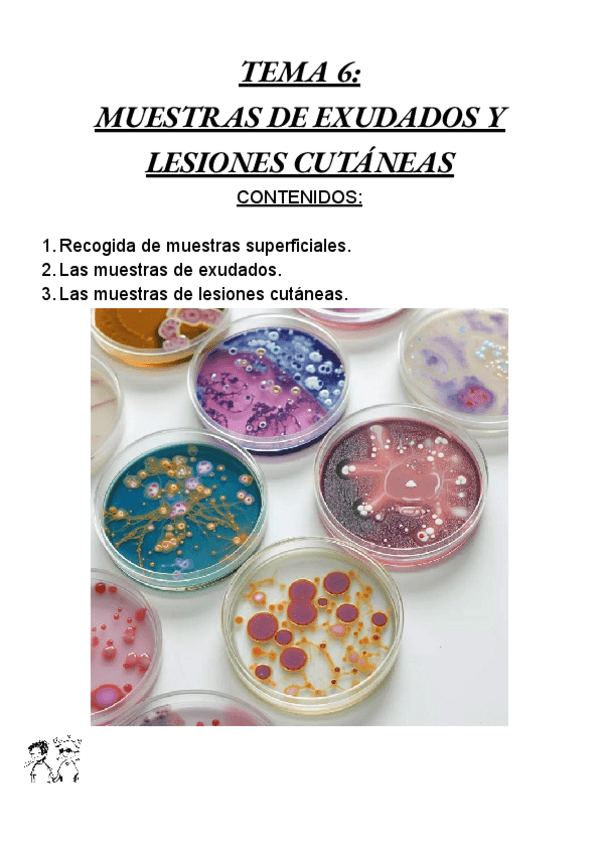

@crokis
Estudios: Anatomía Patológica y Citodiagnóstico
Bio: Apuntes 1° de anatomia
15 Publicaciones
37 Interacciones
1 Seguidores
1 Siguiendo
Lista de publicaciones de crokis
Un trabajo de ayuda para hacerlo después en un canva, etc.
apuntes
-
TGL (libro)
He publicado nuevos apuntes de Técnicas Generales de Laboratorio: TGL (libro)
apuntes
-
GMB
He publicado nuevos apuntes de Gestión de Muestras Biológicas: GMB
He publicado nuevos practicas de Gestión de Muestras Biológicas: informe-GMB-orina.pdf
apuntes
-
BMC
He publicado nuevos apuntes de Biología molecular y citogenética: BMC